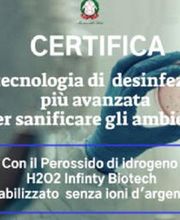
Gallery Cliente

Paolucci Giovanna
Consulenza finanziaria
Via F. Tesei 26, 62010 PollenzaImpresa di pulizie · Addetto alle pulizie
+393381185940 (Telefono)
+393921388357 (ALTERNATE)
Tekno Disinfest si trova a Pollenza Casette Verdini in provincia di Macerata , esegue interventi di sanificazione e disinfezioni, con apposito macchinario che eroga nebbia secca di Perossido di Idrogeno H202, che dà la possibilità di entrare dopo poche ore dallesecuzione dellintervento e con la massima sicurezza, il tutto nel massimo rispetto delle normative vigenti. Avvalendosi di personale altamente qualificato e preparato, la Tekno Disinfest offre diversi servizi di disinfestazione e sanificazione ed è disponibile per eventuali valutazioni per servizi Pest Control come il monitoraggio topi ratti, il monitoraggio insetti striscianti e volanti, le disinfestazioni interne ed esterne contro insetti striscianti e volanti e l'allontanamento volatili. La società è inoltre disponibile per una valutazione di eventuali pulizie ordinarie e straordinarie, manuali e meccanizzate, pulizia fotovoltaico e pareti verticali vetrate fino a 20 mt con sistema unger di depurazione dellacqua, senza utilizzo di piattaforma aerea, fornitura di materiale igienico sanitario, facchinaggio interno, pulizie esterne, giardinaggio.

Via Federico Tesei, 26, 62010 Casette Verdini
Consulenza finanziaria
Via F. Tesei 26, 62010 Pollenza